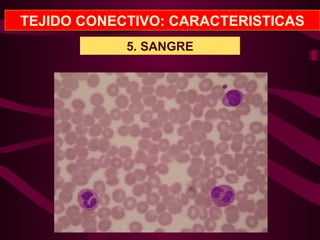
TEJIDO CONECTIVO: CARACTERISTICAS
5. SANGRE

1) La membrana plasmática regula el transporte de materiales dentro y fuera de la célula a través de procesos pasivos como la osmosis y la difusión, y procesos activos como el transporte mediado por proteínas y el transporte en vesículas.
2) El citoplasma contiene organelos como el retículo endoplasmático, mitocondrias y lisosomas que desempeñan funciones vitales como la síntesis de proteínas, la respiración celular y la digestión intracelular.
3)